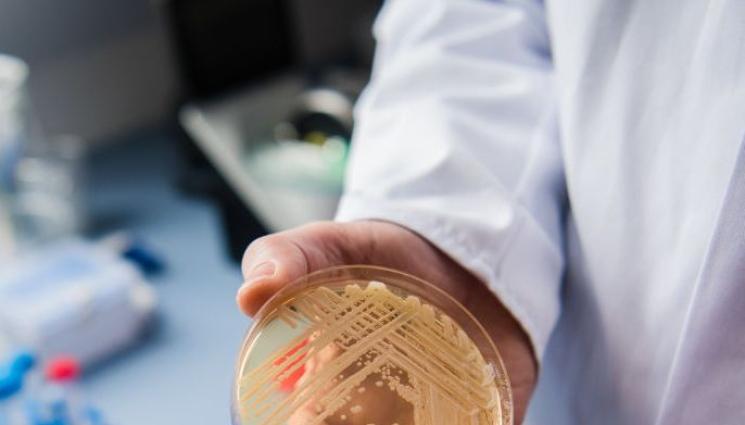
зараза - НОВА ЗАРАЗА: Смъртоносна гъбична инфекция плъзна в САЩ

С мъртоносна гъбична инфекция, която е трудна за лечение, се разпространява с „тревожна“ скорост в САЩ. Заразените почти се удвоиха през 2021 г. от 756 на 1471 случая, се казва в доклад на здравното министерство.
Здравите хора не са изложени на риск от Candida auris, но тези със слаба имунна система или използващи медицински устройства като вентилатори или катетри могат да стигнат до тежко заболяване или да умрат.
Поради тази причина властите го категоризираха като спешна заплаха. Много от пациентите са в домове за възрастни хора. Един на всеки трима пациенти с инвазивни инфекции умира, но може да бъде трудно да се оцени точната роля на Candida auris при уязвимите групи.
Инфекцията е открита за първи път в САЩ през 2016 г. Наблюдава се увеличение на случаите и по света. Миналата година СЗО я включи в списъка си с "гъбични патогени с приоритет".